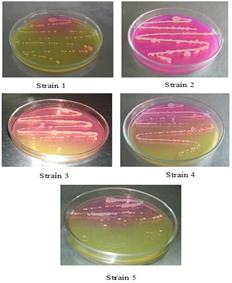

SCREENING AND PRODUCTION OF ANTICARCINOGENIC ENZYME FROM ESCHERICHIA COLI CTLS20: L–ASPARAGINASE
MURUGESAN THANDEESWARANa, RAMASAMY MAHENDRANa, KALARIKKAL GOPIKRISHNAN KIRANa,
K. A. AYUB NAWAZa, MUTHUSAMY PALANISWAMYb, ANGAYARKANNI JAYARAMANa*
aCancer Therapeutics Lab, Department of Microbial Biotechnology, Bharathiar University, Coimbatore 641046, bDepartment of Microbiology, Karpagam University, Coimbatore 641021
Email: angaibiotech@buc.edu.in
Received: 13 Dec 2015 Revised and Accepted: 25 Jan 2016
ABSTRACT
Objective: The objective of this study was attempted to screen the production of L-asparaginase from bacteria isolated from soil samples and its enzymatic activity.
Methods: Screening of L-asparaginase was performed using phenol red indicator growth medium from which the positive strains were chosen based on the colour change. The enzyme production of L-asparaginase was established by submerged fermentation followed by the molecular detection of the efficient bacterial strains.
Results: The enzyme production was undertaken by submerged fermentation with the evaluation of enzymatic activity and protein content. This revealed that the strain Escherichia coli CTLS20 produced a higher yield of L-asparaginase (30.22 IU/mg), 16.91 µg/ml of protein with the specific activity of 1.787 IU/mg when compared with other bacterial strains. The efficient bacterial strains were also confirmed by 16S rRNA sequence as Escherichia coli, Acinetobacter baumnnii, Klebsiella pneumoniae and the phylogenetic tree construction revealed the evolutionary relationship of the bacterial strains.
Conclusion: This study indicated that the bacterial strain E. coli CTLS20 had the ability for the higher production of L-asparaginase. This novel higher yielding bacterial asparaginase is highly desirable as better alternatives in cancer therapy.
Keywords: Soil, L-asparaginase, Submerged fermentation, E. coli, Phylogenetic tree
© 2016 The Authors. Published by Innovare Academic Sciences Pvt Ltd. This is an open access article under the CC BY license (http://creativecommons.org/licenses/by/4.0/)
INTRODUCTION
An antitumor enzyme, L-Asparaginase is a significant group of therapeutic enzymes that accounts for about 40% of the enzyme sales and one-third of the worldwide requirement [1]. L-asparaginase can be effectively treating Acute Lymphoblastic Leukemia (ALL) and Lymphosarcoma that were approved by the Food and Drug Administration (FDA) and World Health Organization (WHO) organizations [2]. The potential interests in this enzyme had also increased with the report when it serves as an anti-neoplastic agent, used for the treatment of Hodgkin disease, chronic lymphocytic leukemia, Reticlesarcoma, and Melanosarcoma [3, 4]. L-Asparaginase (EC 3.5.1.1) belongs to a group of homologous amidohydrolases family, which catalyses the hydrolysis of the amino acid L-asparagine to L-aspartate and ammonia [5].
These L-asparaginases were found in both prokaryotic and eukaryotic organisms. L-asparaginase production by the microbial source is beneficially owing to the cost effective and eco-friendly nature. The microbial production of L-asparaginase was first reported in Escherichia coli [6] whereas the other bacterial strains such as Serratia marcescens [7], Corynebacterium glutamicum [8], Staphylococcus aureus [9], Erwina cartovora [10], Bacillus subtilis [11] and Pseudomonas aeruginosa [12] have also been reported. The fungal strains Aspergillus nidulans [13] and Aspergillus terreus [14] have been reported to produce L-asparaginase. The cytotoxicity of leukemic cells and tumor inhibitory activity has been demonstrated only with L-asparaginase from E. coli, Erwinia aroideae and Serratia marcescens [15]. The finding by Mashburn and Wriston that L-asparaginase derived from Escherichia coli antitumor activity was the same as guinea pig serum and awake the possibility of large scale production of the enzyme for ultimate clinical trial [16]. L-asparaginase from E. coli, the high yields of asparaginase and purification of the enzyme, were in sufficient quantity for human therapy [17]. L-Asparaginase was produced throughout the world by submerged fermentation [18]. It was caused by the yield of the product is several times higher than that other techniques. In other hands, the enzyme properties of L-asparaginase might vary with the microbial source and also the prolonged administrations of L-asparaginase, which causes an anaphylactic shock or neutralization of the drug effect [19]. Therefore, there is a continual need to find out new microbial sources to obtain high-yielding of L-asparaginase producing strains for their therapeutic and industrial applications [20]. In the present study, L-asparaginase enzyme was available from the source of farm soil and the molecular characterization of the microbial strains producing L-asparaginase was determined.
MATERIALS AND METHODS
Collection of soil samples
The soil samples were perceived from the farms of Tamil Nadu Agricultural University, Coimbatore. The soil was clay loam black cotton soil, rich in lime and potash with neutral alkalinity. The samples were serially diluted and plated on nutrient agar plates [21]. The plates were incubated at 37 °C for 24 h. The bacterial isolates were confirmed with the help of Bergey’s Manual of Determinative Bacteriology [22].
Screening of L-asparaginase by plate method
The bacterial isolates were screened for preliminary L-asparaginase activity using the modified-M9 medium. The medium contained Na2HPO4.2H2O, 6 g; KH2PO4, 3 g; NaCl, 0.5 g; L-asparagine, 10 g; 1M MgSO4.7H2O, 2 ml; 0.1 M solution of CaCl2.2H2O, 1 ml; 20 % glucose stock, 10 ml; agar 20 g/l of distilled water. The medium was supplemented with 0.005 % phenol red dye and the pH was adjusted to 6.2. The bacterial isolates were inoculated and incubated at 37 °C for 48 h. After incubation, L-Asparaginase activity was identified based on the intensity of pink color produced on the streaked plates [23].
Screening of L-asparaginase by submerged fermentation
The bacterial strains which showed excellent activity on modified-M9 solid media were further used for the production of L-asparaginase through submerged fermentation. 50 ml of M9 broth was inoculated with bacterial suspension and incubated at 37 °C for 18-20 h on a rotary shaker [24]. Seventy-two hour old cultures were collected and centrifuged at 4 °C for 30 min at 10000 rpm. The pellet was washed three times with sterile, cold distilled water by centrifuging at 10000 rpm for 15 min at 4 °C. The washed pellets were suspended in 0.05 M Tris-hydrochloric acid buffer pH 8.6. Aliquots of the suspended cells were prepared and sonicated by keeping in ice. The sonicated sample was then pooled and centrifuged at 12000 rpm for 15 min at 4 °C. The supernatant was collected and used as a source of the crude enzyme [25].
Assay of L-asparaginase
The samples were mixed with 0.04 M L-asparagine in 0.05 M Tris buffer, pH 7 and 200 µl of sample mixture and incubated for 10 min at 37 °C for the enzymatic reaction. The reaction was incubated with 50 µl of 1.5 M TCA and centrifuged before the addition of Nessler’s reagent to measure the released ammonia after L-asparagine hydrolysis. The measurements were done spectrophotometrically at 450 nm.
International unit (IU) for enzyme activity
One unit of enzyme activity was defined as the amount of enzyme required to release 1 mM of ammonia per minute per ml [µm/ml/min].
Estimation of protein
Protein content was quantified by the method of Lowry et al., [26] using bovine serum albumin as the protein standard.
Molecular identification of bacterial strains
The screened bacteria were then identified by 16S rRNA gene sequencing method. The extraction of DNA from the bacterial species was carried out by the method of Marmur [27] and the purity of DNA was checked by spectrophotometer at 260/280 values. The extracted DNA was viewed by gel documentation unit using 0.8 % agarose gel. The extracted DNA was amplified by using polymerase chain reaction (PCR). The Universal Primer sequences were forward primer (5’-GAGTTTGATCCTGGCTCAG-3’) and reversed primer (5’-ACGGCTACCTTGTTACGACTT-3’). The PCR amplification cycle was carried out with an Eppendrof Master Cycler Personal. The amplification cycle consists 94 °C for 5 min, 30 cycles of 94 °C for 1 min, 56 °C for 1 min, 72 °C for 2 min and a final extension at 72 °C for 10 min. To visualize the amplified PCR product 16 µl volume of the amplified products were subjected to electrophoresis in Tris-borate-EDTA (1X TBE) pH 8 on a 0.8 % agarose gel incorporating 0.01 % ethidium bromide, 8 µl of the DNA ladder (1000bp) were run in parallel to the samples in each gel. The amplified PCR products were visualized under a gel documentation unit.
Phylogenetic tree
The 16S rRNA gene sequences were compared for similarity with the reference species of bacteria contained in the genomic database bank using the NCBI BLAST. Multiple alignments of the sequences were performed using the Clustal W program. The phylogenetic tree was constructed by using treeing algorithms in Mega 5 software.
RESULTS
Forty bacterial isolates obtained as pure cultures were examined for L-asparaginase production using modified M9 medium. In the modified M9 plate media, only five strains showed the ability of the production of L-asparaginase, and this was based on the colour change due to change in pH of the medium (Plate 1). Asparaginase causes the hydrolysis of L-asparaginase into L-aspartic acid and ammonia. The release of ammonia changes pH due to phenol red indicator; it has a pale yellow color with the acidic condition, as the pH changes to alkaline it turns to pink.
Plate 1: Pink colour colonies on modified M9 medium
L-Asparaginase production by submerged fermentation and the crude enzyme was used for the enzymatic activity. L-asparaginase assay was done by the determination of ammonia liberated from L-asparagine by the Nessler’s reaction. The intracellular enzyme was extracted by sonication method. The strain CTLS20 was noted to produce the highest L-Asparaginase activity followed by CTLS30 among all other strains. In contrast, the minimum L-asparaginase production was found in strain CTLS25 (table 1).
Then these efficient L-asparaginase producing organisms were supported by 16S rRNA sequencing. The genomic DNA was isolated from the efficient strains and PCR amplification was performed. The result is obtained by 16S rRNA gene sequencing, and BLAST indicated that the bacterial strains CTLS20, CTL30 and CTL39 were similar to Escherichia coli, CTLS21 as Acinetobacter baumannii and CTLS25 as Klebsiella pneumoniae.
The phylogenetic tree was constructed using MEGA 5 software (fig. 1 to fig. 5). The 16S rRNA sequences were deposited in Genbank and accession number KJ683064, KJ676683 and KJ683063 (E. coli), KJ676684 (A. baumannii) and KJ676685 (K. pneumoniae) were obtained. The results were proved that the highest yielding of L-asparaginase by E. coli strain.
Table 1: Specific activity of L-asparaginase produced by the bacterial strains
S. No. |
Bacterial strains with code |
L–asparaginase crude samples |
||
Enzyme activity (IU/mg) |
Protein concentration (µg/ml) |
Specific activity (IU/mg) |
||
1 |
E. coli CTLS20 |
30.22 |
16.91 |
1.787 |
2 |
A. baumannii CTLS21 |
7.9 |
17.94 |
0.440 |
3 |
K. pneumoniae CTLS25 |
4.62 |
17.31 |
0.266 |
4 |
E. coli CTL30 |
29.2 |
20.37 |
1.433 |
5 |
E. coli CTL39 |
9.16 |
17.84 |
0.513 |

Fig. 1: Phylogenetic tree of Acinetobacter baumannii CTLS21

Fig. 2: Phylogenetic tree of Klebsiella pneumonia CTLS25

Fig. 3: Phylogenetic tree of Escherichia coli CTL 30

Fig. 4: Phylogenetic tree of Escherichia coli CTL 39

Fig. 5: Phylogenetic tree of Escherichia coli CTLS 20
DISCUSSION
Asparaginase is the cornerstone for treatment of Acute Lymphoblastic Leukemia (ALL) and used for treatment in all pediatric regimens [28]. L-asparagine is an essential amino acid for the growth of tumor cells whereas the normal cells do not require the growth. Even though the tumor cells get deprived and cannot survive in the presence of L-asparaginase [29]. Thus, the enzyme L-asparaginase has a great benefit in the cancer treatment.
This study made an attempt to isolate asparaginase producing bacteria from farm soil because an earlier study has clearly shown that soil can provide a rich source of L-asparaginase producing bacteria [30]. For screening of asparaginase producing bacteria on a modified-M9 agar medium was used. This study was correlated to Pradhan et al., [31] which examined L-asparaginase producing bacterial strains through the pink zone formation in the modified-M9 medium. Patil et al., [2] and Ghasemi et al., [23] used in M9 modified agar plug screening based on a change in pH which turned phenol red from yellow to pink and indicated asparaginase activity. Thus, the plate assay is a sensitive but also a rapid method for the screening of asparaginase producing bacterial strains.
L-asparaginase assay was done by the determination of ammonia liberated from L-asparagine by the Nessler’s reaction. Imada et al., [32] and Ahmad et al., [33] reported that the enzyme activities of L-asparaginase in culture filtrate were estimated by Nesslerization process. The strain CTLS20 (E. coli) was observed to produce the highest L-asparaginase activity compared with all other bacterial strains. These findings were strongly correlated to the first report of L-asparagines obtained from E. coli in 1957. The author Mashburn et al., [6] purified the L-asparaginase from E. coli and demonstrated its tumor inhibitory activity. Cedar et al., [34] reported that the L-asparaginase was synthesized at constant rates by E. coli under anaerobic conditions. Similarly, Barnes et al., [35] revealed E. coli A-1 produces L-asparaginase from culture fluid when grew in a small fermentor while the crystal structure of the enzyme from E. coli was studied by Swain et al., [36]. Likewise, Jain et al., [37] observed L-asparaginase from E. coli (VRY-15) reported the highest specific activity of L-asparaginase of about 19.56 µl/mg whereas Muharram et al., [38] observed E. coli had a potential for asparaginase production. The findings of this study also correlate to few of the studies which observed L-asparaginase from Acinetobacter sp. and Klebsiella pneumoniae [12, 39].
In view of literature reports, the yield of L-asparaginase in this study was higher than other studies while those studies were comparing their strains with the reference organisms. Devi et al., [40] found that maximum enzyme activity of Erwina carotovora MTCC 1428 was 0.176 U/8 h at 300 rpm agitations. While Pradhan et al., 2013 [31] identified Bacillus subtilis strain HSWX88 (23.8 IU/ml) was higher than the reference organisms. These results were totally contrasted with the present study that the strain E. coli CTLS20 had produced a higher yield of L-asparaginase (30.22 IU/mg), 16.91 µg/ml of protein with the specific activity of 1.787 IU/mg. It indicated that bacterial strain E. coli CTLS20 could be a potential to produce a higher yield of intracellular L-asparaginase. Further, the purified enzyme from these bacterial strains has been supplied and employed in the clinical application for acute leukemia and another malignant neoplasm in human. The production process of these strains may be optimized for economizing the process.
CONCLUSION
The enzyme L-asparaginase has excellent therapeutic properties and clinically acceptable for its anti-tumor activity. The present study indicated that the microorganisms were capable of producing L-asparaginase especially the motile E. coli had the ability for the higher production of L-asparaginase. This novel higher yielding bacterial asparaginase is highly desirable as better alternatives in cancer therapy. Thus, these organisms may be exploited for large-scale production of L-asparaginase.
CONFLICT OF INTERESTS
All authors have none to declare
REFERENCES
- Warangkar SC, Khobragade CN. Screening, enrichment and media optimization for L–asparaginase production. J Cell Tissue Res 2009;9 Suppl 3:1963-8.
- Mohini Patil P, Ravindra Patil H, Vijay Maheshwari L. A novel and sensitive agar plug assay for screening of asparaginase-producing endophytic fungi from Aeglemarmelos. Acta Biol (Szeged) 2012;56 Suppl 2:175-7.
- Stecher AL, Morgantetti P, De Deus, Polikarpov I, AbrahaoNeto J. Stability of L-asparaginase-an enzyme used in leukemia treatment. Pharm Acta Helv1999;74:1-9.
- Verma NK, Kumar G, Kaur, Anand S. L-asparaginase: a promising chemotherapeutic agent. Crit Rev Biotechnol2007;27:45-62.
- Devarai Santhoskumar, Kota Sobha. L-asparginase from microbes-a comprehensive review. Adv Bio Res 2012;3 Suppl 4:137-57.
- Mash Burn LT, Wriston JC. Tumor inhibitory effect of L-asparaginase from E. coli. Arch Biochem Biophys 1964;105:450-2.
- Stern ML, Phillips AW, Gottlieb AJ. Physical properties of L-asparaginase from Serratia marcescens. J Bacteriol 1976;125:719-27.
- Mesas JM, Gil JA, Martin JF. Characterization and partial purification of L-asparaginase from Corynebacterium glutamicum. J Gen Microbiol 1990;136:515-9.
- Muley RG, Sarker S, Ambedkar S, Nail SR. Influence of alkali-treated corn steep liquor containing medium on protein production by Staphylococcus aureus. Folia Microbiol 1998;43:31-4.
- Aghaiypour K, Wlodawer A, Lubkowski J. Structural basis for the activity and substrate specificity of Erwinia chrysanthemi L-asparaginase. Biochemistry 2001;40:5655-64.
- Fisher SH, Wray LV. Bacillus subtilis168 contains two differentially regulated genes encoding L-asparaginase. J Bacteriol 2002;184:2148-54.
- Ashraf El-Bessoumy A, Mohamed Sarhan, Jehan Mansour. Production, isolation and purification of L-asparaginase from Pseudomonas aeruginosa 50071 using solid state fermentation. J Biochem Mol Biol 2004;37:387-93.
- Drainas C, Pateman JA. L-Asparaginase activity in the fungus Aspergillus nidulans. Biochem Soc Trans 1977;5:259-61.
- Sarquis MI, Oliveira EM, Santos AS, Costa GL. Production of L-asparaginase by filamentous fungi. Mem Inst Oswaldo Cruz 2004;99:489-92.
- Debajit Borah, Yadav RNS, Ankush Sangra, Lubana Shahin, Anand Kumar Chaubey. Production, purification and process optimization of asparaginase (an anticancer enzyme) from E. coli isolated from sewage water. Asian J Pharm Clin Res 2012;5:202-4.
- Mashburn LT, Wriston TJC. Tumor inhibitory effect of L-asparaginase from Escherichia coli. Archives Biochem Biophy 1964;105:451-2.
- Sreepad Jois, Shilpa Chandru, Ashajyothi Chavan, Ramachandra Yarapa Lakshmikantha, Padmalatha Rai Satwadi. Study on production, purification, and characterisation of L-asparaginase from Escherichia coli and Pseudomonas aeruginosa. Int J Pharm Chem Biol Sci 2013;3 Suppl 3:565-70.
- Saleem Basha N, Rekha R, Komala M, Ruby S. Production of extracellular anti-leukaemic enzyme L-asparaginase from marine actinomycetes by solid state and submerged fermentation: purification and characterisation. Trop J Pharm Res 2009;8 Suppl 4:353-60.
- Rati Kumari Sinha, Hare Ram Singh, Santosh Kumar Jha. Production, purification and kinetic characterization of L-asparaginase from Pseudomonas fluorescens. Int J Pharm Sci 2015;7:135-8.
- Ramraj Upadhyay, Akanksha Saxena, Naveen Kango. Screening and production of tumor inhibitory L-Asparaginase by bacteria isolated from soil. Asian J Pharm Clin Res 2012;5 Suppl 3:135-7.
- Dubey RC, Maheshwari DK. Practical microbiology. S Chand Limited. India; 2002. p. 286-91.
- John Holt G. Bergey’s manual of determinative bacteriology. 9th Edition. United States of America; 2000.
- Younes Ghasemi, Alireza Ebrahiminezhad, Sara Rasoul-Amini, Gholamreza Zarrini, Mohammad Bagher Ghoshoon, Mohammad Javad Raee, et al. An optimized medium for the screening of L-asparaginase production by Escherichia coli. Am J Biochem Biotechnol 2008;4 Suppl 4:422-4.
- Heinemann B, Howard AJ. Production of tumor-inhibitory L-asparaginase by submerged growth of Serratia marcescens. Appl Microbiol 1969;18:550-4.
- Levenberg B, Hayaishi O. A bacterial pterin deaminase. J Biol Chem 1959;234:955-61.
- Lowry OH, Rosebrough NJ, Farr AL, Randall RJ. Protein measurement with folin phenol reagent. J Biol Chem 1951;193:265-75.
- Marmur J. A procedure for the isolation of deoxyribonucleic acid from micro-organisms. J Mol Biol 1961;3 Suppl 2:208.
- Richa Jain, Zaidi KU, Yogita Verma, Pooja Saxena. L-asparaginase: a promising enzyme for the treatment of acute lymphoblastic leukaemia. Peoples J Sci Res 2012;5 Suppl 1:29-35.
- Kumar Jha S, Divya Pasrija, Rati Kumari Sinha, Hare Ram Singh, Vinod Kumar Nigam, Ambrish Sharan Vidyarthi. Microbial L-asparaginase: a review on current scenario and future prospects. Int J Pharma Sci Res 2012;3 Suppl 9:3076-90.
- Kamble KD, Bidwe PR, Muley VY, Kamble LH, Bhadange DG, Musaddiq M. Characterization of L-Asparaginase producing bacteria from water, farm and saline soil. J Biosci Dis 2012;3 Suppl 1:116-9.
- Biswaprakash Pradhan, Sashi Dash K, Sabuj Sahoo. Screening and characterization of extracellular L-asparaginase producing Bacillus subtilis strain hswx88, isolated from taptapanihotspring of odisha, India. Asian Pac J Trop Biomed 2013;3:936-41.
- Imada A, Igarasi S, Nakahama K, Isono M. Asparaginase and glutaminase activities of microorganisms. J Gen Microbiol 1973;76:85-99.
- Ahyar Ahmad, Abdul Muis Patta, Hasnah Natsir. Purification and immobilization of L-asparaginase enzyme from the thermophilic bacteria Bacillus licheniformis strain HSA3-1a. Int J Pharm Biol Sci 2013;4 Suppl 4:274-80.
- Cedar H, Schwartz JH. Production of L-asparaginase II by Escherichia coli. J Bacteriol 1968;96:2043-8.
- Barnes WR, Vela GR, Dorn GL. Physiology of L-asparaginase synthesis in recombinants of Escherichia coli A-1. Appl Environ Microbiol 1978;35:766-70.
- Swain AL, Jasklski M, Houssett D, Mohana Rao JK, Alexander W. Crystal structure of Escherichia coli L-asparaginase, an enzyme used in cancer therapy. Proc Natl Acad Sci USA1993;90:1474-8.
- Richa Jain, Zaidi KU, Yogita Verma, Pooja Saxena. L-Asparaginase: a promising enzyme for the treatment of acute lymphoblastic leukaemia. Peoples J Sci Res 2012;5 Suppl 1:29-35.
- Muharram MM, Abulhamd AT, Mounir M, Salem Bekhet. Recombinant expression, purification of L-Asparaginase-II from thermotolerant E. coli strain and evaluation of its antiproliferative activity. Afr J Microbiol Res 2014;8 Suppl 15:1610-9.
- Niharika Yadav, Supriya Sarkar. Production of L-asparaginase by Fusarium oxysporum using submerged fermentation. Int J Pharm Sci Invent 2014;3 Suppl 6:32-40.
- Sarita Devi, Aditya Kulshreshtha, Ashutosh Kumar Rai, Wamik Azmi. Bench-scale production of L-asparaginase from Erwinia carotovora in a laboratory fermenter. Int J Life Sci Pharma Res 2012;2 Suppl 3:25-35.